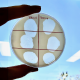
Del laboratorio al campo

Del laboratorio al campo
Placas de lisis producidas por bacteriófagos Teros 13 y Teros 14 sobre cesped bacteriano de PSS.
La vinculación entre la investigación realizada en laboratorio y el trabajo hecho en campo, es fundamental, tanto para el entendimiento de las problemáticas enfrentadas por los agricultores, como para el desarrollo de innovaciones que nos permitan superar estos desafíos. Particularmente en cerezos, una de las enfermedades que mayormente inciden en estos cultivos, es el cáncer bacteriano causado por Pseudomonas syringae pv. syringae (PSS), la cual, a través de la secreción de toxinas específicas, facilita la destrucción de los tejidos vegetales y la disminución del vigor de las plantas, afectando la productividad de los huertos.
El concepto de agricultura sustentable plantea la aplicación de un conjunto de prácticas para reducir las poblaciones de patógenos a niveles tolerables, minimizando el uso de plaguicidas químicos y apuntando a una cadena productiva inocua.
En Agroadvance, empresa chilena de biotecnología, nos propusimos como objetivo investigar y desarrollar productos sustentables de origen biológico, con un marcado potencial de innovación y efectividad en la protección frente a enfermedades de importancia económica, entre las que encontramos el cáncer bacteriano en cerezos.
Como punto de partida en nuestra investigación, el primer paso fue el aislamiento de diferentes cepas de PSS desde diversos huertos afectados, las que luego fueron caracterizadas según su capacidad de producir daño. Este paso, fundamental para el entendimiento de la enfermedad, nos permitió obtener y estudiar las bacterias más virulentas en los campos y también acceder a sus genomas y, por ende, establecer metodologías moleculares para la identificación y cuantificación de PSS mediante la reacción de la polimerasa en cadena (qPCR).

Medias con una letra común no son significativamente diferentes (p>0,05). Fuente: Caducos SPA, Asesoría en fruticultura, I+D.
La cuantificación molecular del patógeno, nos ha permitido realizar un monitoreo preciso y específico de la enfermedad en los campos, fundamental para entender la dinámica poblacional de PSS y el movimiento de la bacteria a lo largo del ciclo fenológico del cerezo. Adicionalmente, en los últimos años hemos realizado monitoreos para estudiar la eficacia a nivel de campo de programas de aplicación con uso de cobres y antibióticos sobre el nivel de inoculo de PSS.
En 2016, Agroadvance inició su segunda fase de investigación, dando lugar al aislamiento de diferentes bacteriófagos infectivos de PSS. Los bacteriófagos son virus especializados en infectar bacterias como parte de su ciclo reproductivo, causando la destrucción de estas durante su propagación. En este contexto, la implementación de bacteriófagos surge como una estrategia sustentable e innovadora para mantener huertos saludables y protegidos ante eventuales enfermedades. Sin embargo, encontrar bacteriófagos con un alto valor biotecnológico no es una tarea sencilla:

- Estos virus deben ser capaces de infectar diferentes variantes bacterianas (cepas) del patógeno de interés, con la finalidad de cubrir un amplio rango de protección frente a microorganismos dañinos.
- Es importante considerar que los bacteriófagos deben ser tolerantes y efectivos frente a temperaturas y condiciones de radiación UV encontrados en campo, entre otros parámetros físico-químicos que podrían afectar la viabilidad y efectividad de estos virus.
- Estos deben tener una óptima viabilidad en el tiempo y ser compatibles con parámetros de escalamiento productivo. Durante la segunda fase de investigación en Agroadvance, se seleccionaron bacteriófagos capaces de lisar una amplia variedad de cepas de PSS, incluyendo aquellas cepas más virulentas aisladas previamente en nuestros laboratorios. Los virus, elegidos según su potencial biotecnológico, fueron secuenciados mediante técnicas de secuenciación masivas para el análisis de sus genomas, con especial énfasis en el estudio de aquellos genes codificantes de proteínas asociadas al proceso de infección viral. Los candidatos seleccionados, fueron liofilizados mediante un proceso de criodesecación, y posteriormente incorporados en nuestras formulaciones biológicas para ser aplicados vía foliar en evaluaciones de invernadero y campo. Los resultados obtenidos en nuestros ensayos demostraron la efectividad de las formulaciones en la protección frente a PSS, reforzando la importancia de la incorporación de estos microorganismos en el manejo de huertos de cerezos.










